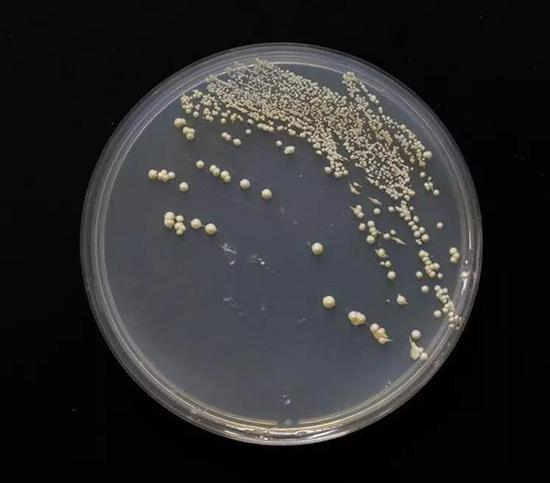
SY14菌落形态

来源:科学大院
酿酒酵母大家都不陌生,我们日常做啤酒做面包都离不开它,它本来有16条染色体,可你见过只有单条染色体的酿酒酵母吗?
中国科学院分子植物科学卓越创新中心/植物生理生态研究所覃重军研究员研究组成功构建了“单条染色体的酿酒酵母”,相关论文于北京时间2018年8月2日在线发表于国际顶尖学术期刊《Nature》上。
这是世界首例“单条染色体真核细胞”,是地地道道的中国制造,同时也是合成生物学和“人造生命”领域的里程碑式的进展!论文共同的通讯作者为中国科学院分子植物科学卓越创新中心/植物生理生态研究所的薛小莉副研究员,中国科学院生物化学与细胞生物学研究所的周金秋研究员和中国科学院分子卓越创新中心/植物生理生态研究所的赵国屏院士。

覃重军研究员研究组成员
单染色体的酿酒酵母诞生
酿酒酵母原本含有16条染色体,经过基因编辑技术(CRISPR/Cas9)及利用酿酒酵母高同源重组能力进行染色体融合,覃重军研究组及合作者实验室最终获得了只有一条染色体的酿酒酵母真核细胞。
这项研究历经4年,通过15轮染色体融合,成功将天然酿酒酵母单倍体细胞的16条染色体融合为1条,该酿酒酵母菌株被命名为SY14。
SY14菌落形态
颠覆了染色体三维结构决定基因时空表达的观念
如此大幅度的改动酿酒酵母的染色体结构,是否会对它的三维结构产生影响呢?答案是肯定的,但是这种影响,并没有影响到酿酒酵母细胞的功能。
将十六条染色体融合成一条,使SY14的染色体三维结构也发生了巨大变化,野生的酿酒酵母细胞的染色体“整齐有序”,像一朵含苞待放的花苞,而SY14则“杂乱无序”,更接近球形结构(图2)。但是如此巨大的改变,几乎不影响SY14的基因表达和细胞功能,从而颠覆了染色体三维结构决定基因时空表达的传统观念。

图2:野生型酿酒酵母与人造单染色体酵母SY14的细胞形态及染色体三维结构对比
构建“单条染色体酵母”有什么意义?
生物学教科书中将自然界存在的生命体分为具有被核膜包裹染色体细胞核的真核生物和染色体裸露无核膜包裹的原核生物,真核生物通常含有多条线型结构的染色体,而原核生物通常含有一条环型结构的染色体。而SY14这种单条染色体真核细胞的“诞生”,突破了人们对于真核生物和原核生物界限的传统认知。
细胞衰老是生物在生命过程中整个机体形态、结构和功能逐渐衰退的综合现象。生物的机体由细胞构成,生命的衰老起始于细胞的老化。而细胞的老化又与端粒有着密不可分的关系。
端粒是真核细胞线性染色体末端非编码的DNA 重复序列和与之相连的端粒结合蛋白的功能性复合体。端粒的主要作用保护染色体末端免于融合和退化,在染色体定位、复制、保护和控制细胞生长及寿命方面具有重要作用,并与细胞凋亡、细胞转化和永生化密切相关。当细胞分裂一次,每条染色体的端粒就会逐次变短一些。
人类的过早衰老与染色体的端粒长度直接相关,端粒的缩短还与许多疾病相关。与天然酵母的32个端粒相比,SY14酵母的单条线性染色体仅有2个端粒。由于酿酒酵母三分之一基因与人类基因同源,单染色体酵母细胞为研究人类端粒功能及细胞衰老提供了很好的模型,并且对于人类疾病的防治具有重要意义。

染色体端粒(来自百度百科)
为什么采用酿酒酵母细胞进行改造?
原因有三点:
1、酿酒酵母是最简单的真核模式生物。
2、酿酒酵母遗传背景清晰,基因功能研究较为完整。
3、酿酒酵母同源重组能力很高,遗传操作方便。
合成生物学到底是什么?
“合成生物学”就是用人工合成的方法,对现有的、天然存在的生物系统进行重新设计和改造,或者通过人工的方法,创造自然界不存在的“人造生命”。
从本质上来说,合成生物学是在分子水平上对生命系统的重新设计和改造,基因工程、代谢工程、蛋白质工程等技术是其核心的技术手段。
因此,在人工设计的指导下,在简约的“细胞”或“系统”底盘上,构建人工生物系统并实现其运行的优化。该项研究也是基于此,将天然复杂的生命体系(具有十六条染色体的酿酒酵母真核细胞)通过人工干预变简约(具有单条染色体的酵母真核细胞),从而构建人工“创造”自然界不存在的生命。
展望
单染色体酵母的诞生打破了我们对传统合成生物学的固有认知,为生命科学另辟了一条蹊径,也是人类历史上的一次重大飞跃!同时,人工构建的一系列染色体融合的酵母菌株为人类染色体端粒与细胞衰老、肿瘤形成提供了模型。
合成生物学的魅力正是通过重塑去重新认知,而这项震惊国际的成果也为进化和演化提供了全新的探索。



